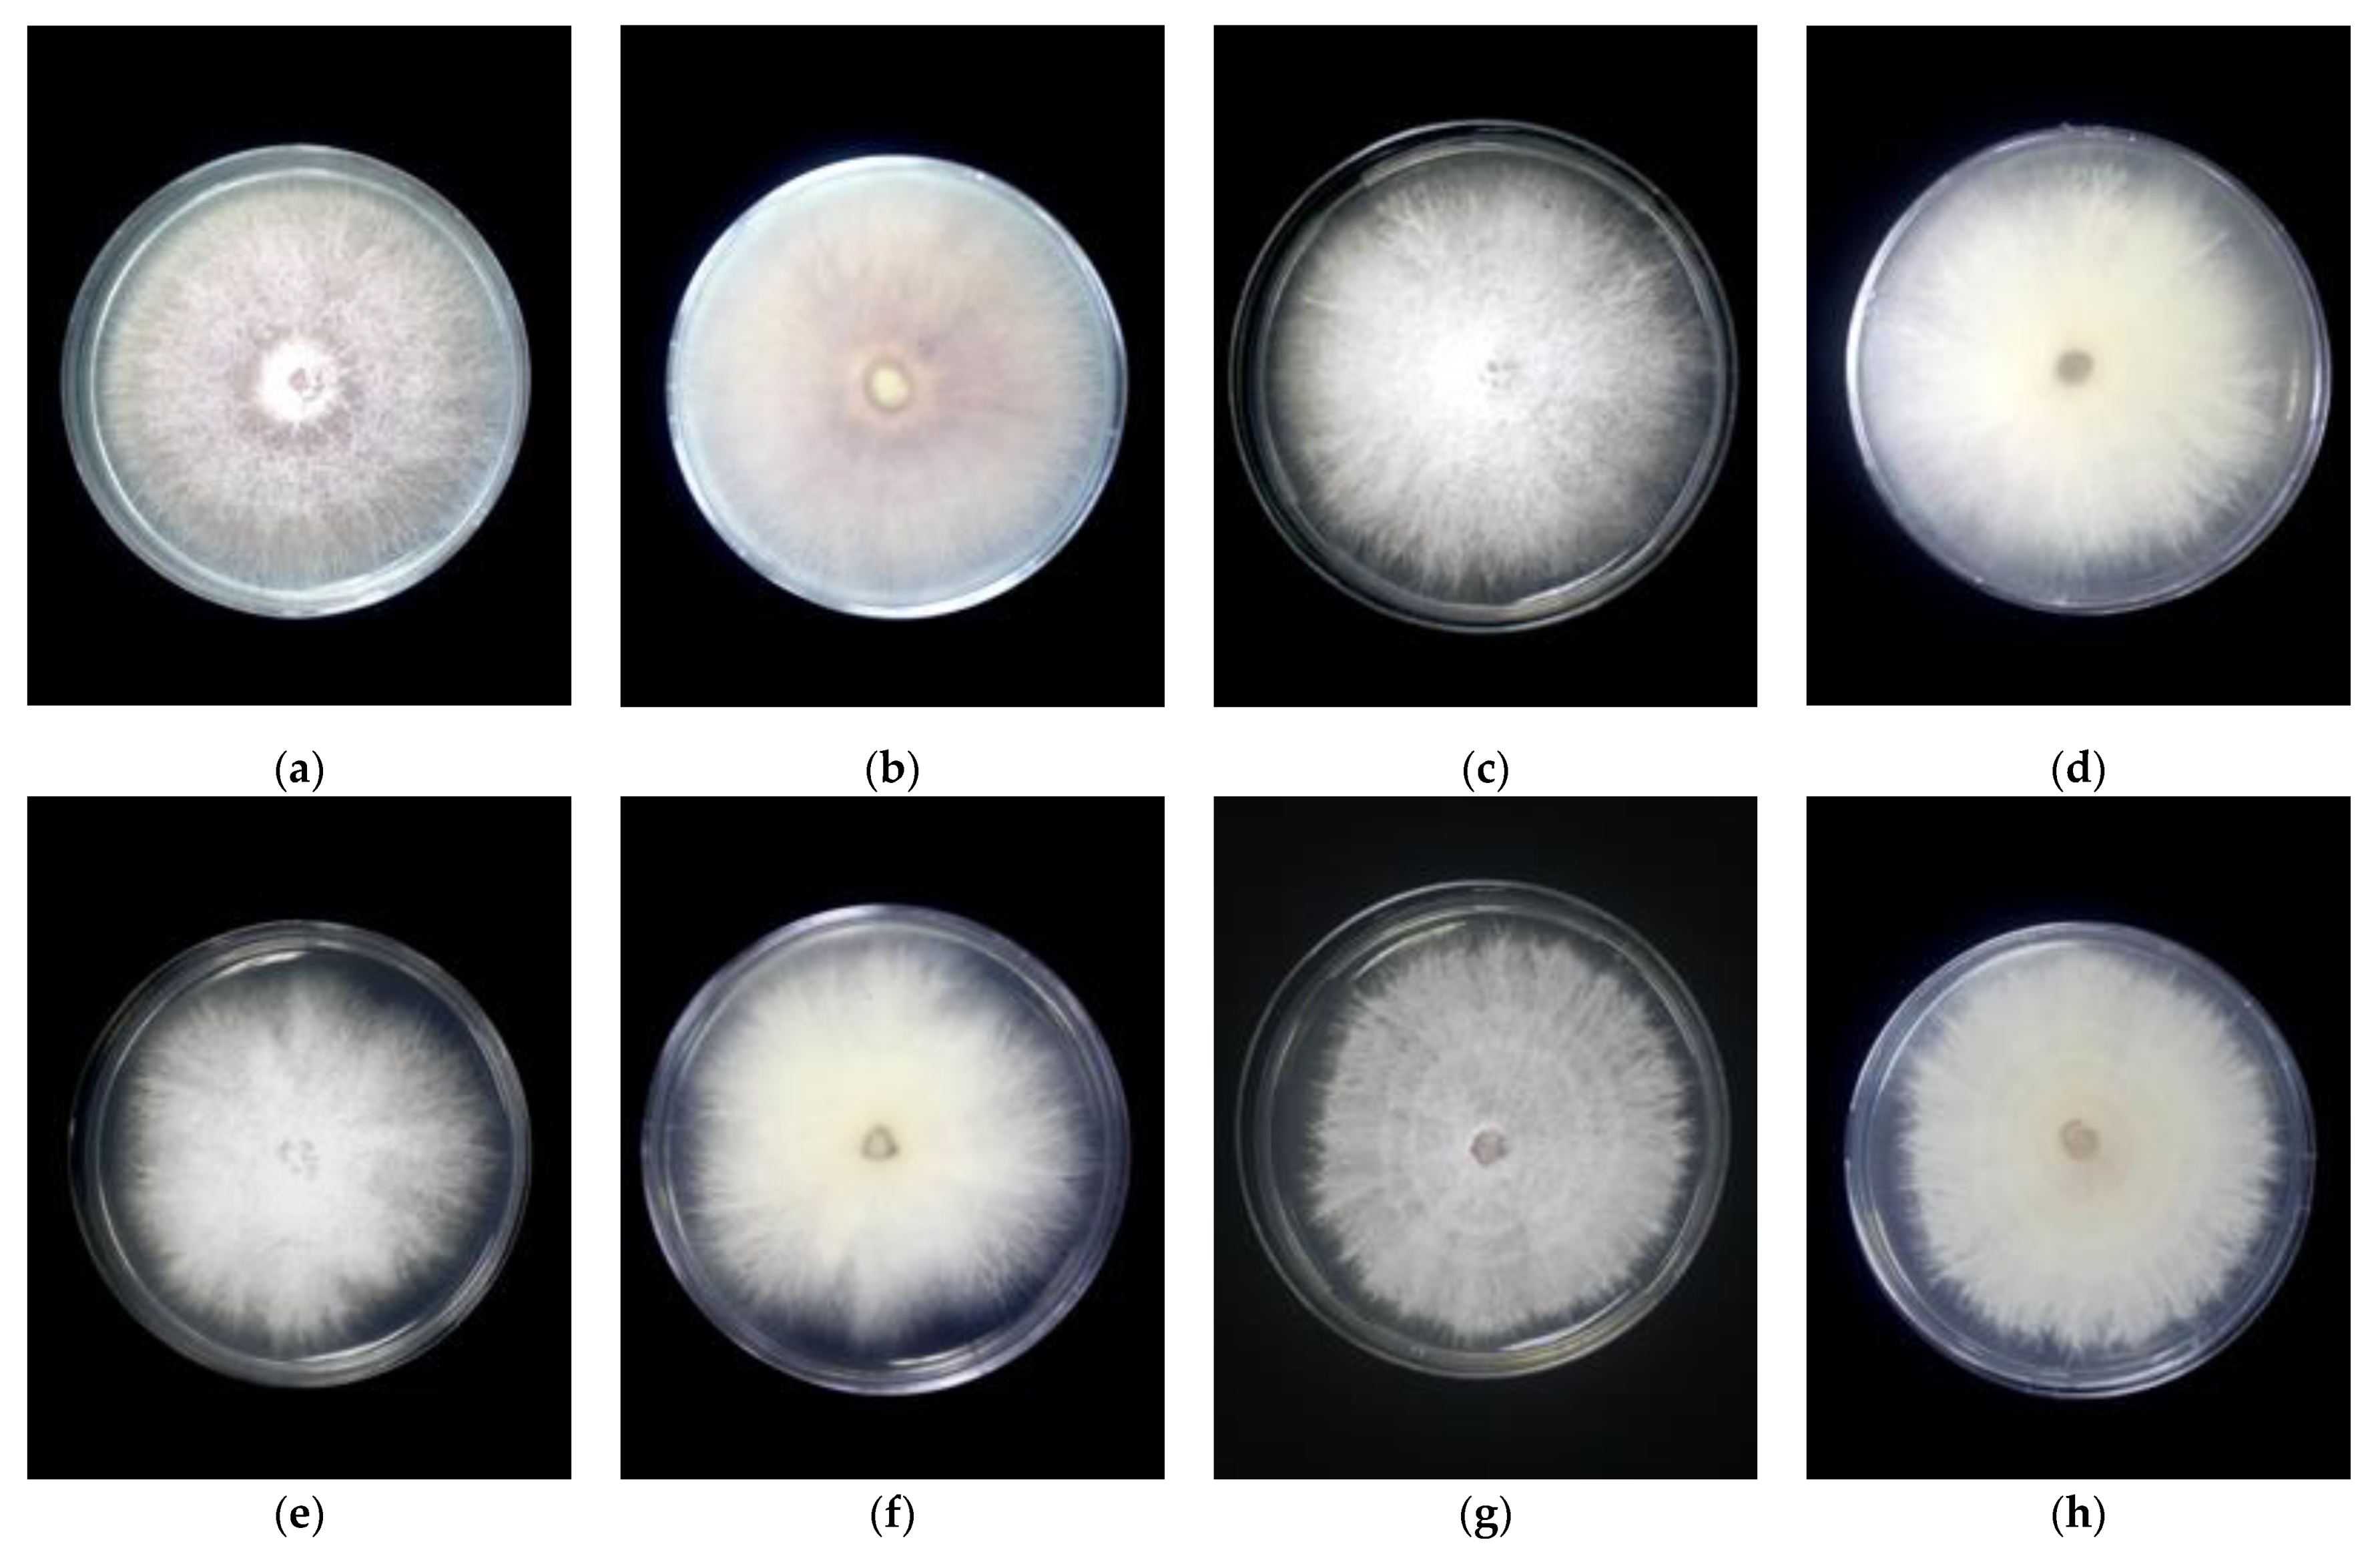
Agronomy 11 01955 g001

Current Classification and Diversity of Fusarium Species Complex, the Causal Pathogen of Fusarium Wilt Disease of Banana in Malaysia
Abstract
:1. Introduction
2. Materials and Methods
2.1. Sample Collection
2.2. Morphological Identification of Fusarium Species
2.3. Molecular Identification of Fusarium Species
2.4. Phylogenetic Analysis
2.5. Pathogenicity Test
2.6. Statistical Analysis
3. Results
3.1. Morphological Identification
3.2. Molecular Analysis
3.3. Pathogenicity Test
4. Discussion
5. Conclusions
Supplementary Materials
Author Contributions
Funding
Institutional Review Board Statement
Informed Consent Statement
Acknowledgments
Conflicts of Interest
References
- Ploetz, R.C. Fusarium wilt of banana. Phytopathology 2015, 105, 1512–1521. [Google Scholar] [CrossRef] [PubMed] [Green Version]
- Mostert, D.; Molina, A.B.; Daniells, J.; Fourie, G.; Hermanto, C.; Chao, C.P.; Fabregar, E.; Sinohin, V.G.; Masdek, N.; Thangavelu, R.; et al. The distribution and host range of the banana Fusarium wilt fungus, Fusarium oxysporum f. sp. cubense in Asia. PLoS ONE 2017, 12, e0181630. [Google Scholar] [CrossRef] [PubMed] [Green Version]
- FAO Banana Market Review. 2018. Available online: http://www.fao.org/fileadmin/templates/est/COMM_MARKETS_MONITORING/Bananas/Documents/Banana_Market_Review_Prelim_Results_2018.pdf (accessed on 4 March 2019).
- Ploetz, R.; Pegg, K. Fusarium wilt of banana and Wallace’s line: Was the disease originally restricted to his Indo-Malayan region? Australas. Plant Pathol. 1997, 26, 239–249. [Google Scholar] [CrossRef]
- Su, H.J.; Hwang, S.C.; Ko, W.H. Fusarium wilt of Cavendish bananas in Taiwan. Plant Dis. 1986, 70, 814–818. [Google Scholar]
- Maryani, N.; Lombard, L.; Poerba, Y.S.; Subandiyah, S.; Crous, P.W.; Kema, G.H.J. Phylogeny and genetic diversity of the banana Fusarium wilt pathogen Fusarium oxysporum f. sp. cubense in the Indonesian centre of origin. Stud. Mycol. 2019, 92, 155–194. [Google Scholar] [CrossRef]
- Ploetz, R.C. Management of Fusarium wilt of banana: A review with special reference to tropical race 4. Crop. Prot. 2015, 73, 7–15. [Google Scholar] [CrossRef]
- Malik, T.M.T.A.; Roff, M.N.M.; Rozeita, L.; Maimun, T. Socio-economic Impact, Research and Development, and Policy-making: Regulatory of Fusarium Wilt on Banana in Malaysia. Retrived Dec. 2013, 26, 2019. [Google Scholar]
- Leong, S.K.; Latiffah, Z.; Baharuddin, S. Genetic diversity of Fusarium oxysporum f. sp. cubense isolates from Malaysia. Afr. J. Microbiol. Res. 2010, 4, 1026–1037. [Google Scholar]
- Wong, C.K.F.; Zulperi, D.; Vadamalai, G.; Saidi, N.B.; Teh, C.Y. Phylogenetic Analysis of Fusarium oxysporum f. sp. cubense Associated with Fusarium Wilt of Bananas from Peninsular Malaysia. Sains Malays. 2019, 48, 1593–1600. [Google Scholar] [CrossRef]
- Leslie, J.F.; Summerell, B.A. The Fusarium Laboratory Manual, 1st ed.; Blackwell Publishing Ltd.: Milton, Australia, 2008. [Google Scholar]
- Glass, N.L.; Donaldson, G.C. Development of primer sets designed for use with the PCR to amplify conserved genes from filamentous ascomycetes. Appl. Environ. Microb. 1995, 61, 1323–1330. [Google Scholar] [CrossRef] [PubMed] [Green Version]
- Jiménez-Gasco, M.M.; Milgroom, M.G.; Jiménez-Díaz, R.M. Gene genealogies support Fusarium oxysporum f. sp. ciceris as a monophyletic group. Plant Pathol. 2002, 51, 72–77. [Google Scholar] [CrossRef] [Green Version]
- Zeng, L.; Liu, W.; Zhao, Z.; Wang, F.; Zhou, J.; Li, H.; Du, C.-X. The identification on race of Fusarium oxysporum f. sp. cubense based on multi-gene sequence analysis. Mycosystema 2014, 33, 867–882. [Google Scholar] [CrossRef]
- Geiser, D.M.; Jiménez-Gasco, M.D.M.; Kang, S.; Makalowska, I.; Veeraraghavan, N.; Ward, T.J.; Zhang, N.; Gretchen, A.K.; O’Donnell, K. FUSARIUM-ID v. 1.0: A DNA sequence database for identifying Fusarium. Eur. J. Plant Pathol. 2004, 110, 473–479. [Google Scholar] [CrossRef]
- O’Donnell, K.; Kistler, H.C.; Cigelnik, E.; Ploetz, R.C. Multiple evolutionary origins of the fungus causing Panama disease of banana: Concordant evidence from nuclear and mitochondrial gene genealogies. Proc. Natl. Acad. Sci. USA 1998, 95, 2044–2049. [Google Scholar] [CrossRef] [Green Version]
- Fisher, N.L.; Burgess, L.W.; Toussoun, T.A.; Nelson, P.E. Carnation Leaves as a Substrate and for Preserving Cultures of Fusarium species. Phytopathology 1982, 72, 151–153. [Google Scholar] [CrossRef]
- Nirenberg, H.I. A simplified method for identifying Fusarium spp. occurring on wheat. Can. J. Bot. 1981, 59, 1599–1609. [Google Scholar] [CrossRef]
- Chupp, C. Further Notes on Double Cover-Glass Mounts. Mycologia 1940, 32, 269–270. [Google Scholar] [CrossRef]
- Schneider, C.A.; Rasband, W.S.; Eliceiri, K.W. NIH Image to ImageJ: 25 years of image analysis. Nat. Methods 2012, 9, 671–675. [Google Scholar] [CrossRef]
- Umesha, S.; Manukumar, H.M.; Raghava, S. A rapid method for isolation of genomic DNA from food-borne fungal pathogens. 3 Biotech 2016, 6, 123. [Google Scholar] [CrossRef] [Green Version]
- Dita, M.A.; Waalwijk, C.; Buddenhagen, I.W.; Souza, J.T.; Kema, G.H.J. A molecular diagnostic for tropical race 4 of the banana Fusarium wilt pathogen. Plant Pathol. 2010, 59, 348–357. [Google Scholar] [CrossRef]
- Kumar, S.; Stecher, G.; Tamura, K. MEGA7: Molecular Evolutionary Genetics Analysis Version 7.0 for Bigger Datasets. J. Mol. Evol. 2016, 33, 1870–1874. [Google Scholar] [CrossRef] [Green Version]
- Swofford, D.L. PAUP^*: Phylogenetic Analysis Using Parsimony (and Other Methods) 4.0 b8; Sinauer: Sunderland, MA, USA, 2001. [Google Scholar]
- Stamatakis, A. RAxML-VI-HPC: Maximum likelihood-based phylogenetic analyses with thousands of taxa and mixed models. Bioinformatics 2006, 22, 2688–2690. [Google Scholar] [CrossRef]
- Bouckaert, R.; Vaughan, T.G.; Barido-Sottani, J.; Duchêne, S.; Fourment, M.; Gavryushkina, A.; Heled, J.; Jones, G.; Kühnert, D.; De Maio, N.; et al. BEAST 2.5: An advanced software platform for Bayesian evolutionary analysis. PLoS Comput. Biol. 2019, 15, e1006650. [Google Scholar] [CrossRef] [PubMed] [Green Version]
- García-Bastidas, F.A.; Van der Veen, A.J.T.; Nakasato-Tagami, G.; Meijer, H.J.G.; Arango-Isaza, R.E.; Kema, G.H.J. An Improved Phenotyping Protocol for Panama Disease in Banana. Front. Plant Sci. 2019, 10, 1006. [Google Scholar] [CrossRef] [PubMed] [Green Version]
- Cody, R. Biostatistic by Example Using SAS ® Studio, 2nd ed.; SAS Institutle Inc: Cary, NC, USA, 2016; pp. 113–128. [Google Scholar]
- O’Donnell, K.; Ward, T.J.; Robert, V.A.; Crous, P.W.; Geiser, D.M.; Kang, S. DNA sequence-based identification of Fusarium: Current status and future directions. Phytoparasitica 2015, 43, 583–595. [Google Scholar] [CrossRef] [Green Version]
- Roger, A.J.; Sandblom, O.; Doolittle, W.F.; Philippe, H. An evaluation of elongation factor 1 alpha as a phylogenetic marker for eukaryotes. Mol. Biol. Evol. 1999, 16, 218–233. [Google Scholar] [CrossRef] [Green Version]
- Liu, S.; Wu, B.; Lv, S.; Shen, Z.; Li, R.; Yi, G.; Li, C.; Guo, X. Genetic Diversity in FUB Genes of Fusarium oxysporum f. sp. cubense Suggests Horizontal Gene Transfer. Front. Plant Sci. 2019, 10, 1069. [Google Scholar] [CrossRef] [PubMed]
- Bentley, S.; Pegg, K.G.; Moore, N.Y.; Davis, R.D.; Buddenhagen, I.W. Genetic variation among vegetative compatibility groups of Fusarium oxysporum f. sp. cubense analysed by DNA fingerprinting. Phytopathology 1998, 88, 1283–1293. [Google Scholar] [CrossRef] [PubMed] [Green Version]
- Maryani, N.; Sandoval-Denis, M.; Lombard, L.; Crous, P.W.; Kema, G.H.J. New endemic Fusarium species hitch-hiking with pathogenic Fusarium strains causing Panama disease in small-holder banana plots in Indonesia. Persoonia 2019, 43, 48. [Google Scholar] [CrossRef] [Green Version]
- Matsumoto, K.; Barbosa, M.L.; Souza, L.A.C.; Teixeira, J.B. Race 1 Fusarium wilt tolerance on banana plants selected by fusaric acid. Euphytica 1995, 84, 67–71. [Google Scholar] [CrossRef]
- Ploetz, R.C. Fusarium wilt of banana is caused by several pathogens referred to as Fusarium oxysporum f. sp. cubense. Phytopathology 2006, 96, 653–656. [Google Scholar] [CrossRef] [Green Version]
- Chen, A.; Sun, J.; Matthews, A.; Armas-Egas, L.; Chen, N.; Hamill, S.; Mintoff, S.; Tran-Nguyen, L.T.; Batley, J.; Aitken, E.A. Assessing Variations in Host Resistance to Fusarium oxysporum f. sp. cubense Race 4 in Musa Species, with a Focus on the Subtropical Race 4. Front. Microbiol. 2019, 10, 1062. [Google Scholar] [CrossRef] [PubMed] [Green Version]
- Dale, J.; James, A.; Paul, J.Y.; Khanna, H.; Smith, M.; Peraza-Echeverria, S.; Garcia-Bastidas, F.; Kema, G.; Waterhouse, P.; Mengersen, K.; et al. Transgenic Cavendish bananas with resistance to Fusarium wilt tropical race 4. Nat. Commun. 2017, 8, 1496. [Google Scholar] [CrossRef] [PubMed] [Green Version]

| Sample Location | GPS Coordinate | Parts Sampled | Sample Code | GenBank Accessions | |
|---|---|---|---|---|---|
| TEF-1a | HIS H3 | ||||
| Universiti Putra Malaysia, Selangor | N 2 59.510 E 101 42.963 | Stem | MUCC2830 | LC545806 | LC545766 |
| Kluang, Johor | N 2 02.996 E 103 17.847 | Stem | MUCC2831 | LC545832 | LC545774 |
| Batu Pahat, Johor | N 1 50.863 E 103 05.339 | Root | MUCC2832 | LC545800 | LC545770 |
| Batu Pahat, Johor | N 1 52.001 E 102 55.593 | Stem | MUCC2833 | LC545831 | - |
| Ayer Hitam, Johor | N 1 56.237 E 103 11.050 | Stem | MUCC2834 | LC545830 | LC545775 |
| Ayer Hitam, Johor | N 1 56.237 E 103 11.050 | Stem | MUCC2835 | LC545829 | LC545776 |
| Ayer Hitam, Johor | N 1 56.237 E 103 11.050 | Stem | MUCC2836 | LC545833 | LC545777 |
| Jasin, Melaka | N 2 18.912 E 102 25.800 | Soil | MUCC2837 | LC545828 | LC545778 |
| Kuala Pilah Tengah, Negeri Sembilan | N 2 41.494 E 102 11.839 | Corm | MUCC2838 | LC545827 | LC545779 |
| Jabatan Pertanian Lekir, Perak | N 4 08.673 E 100 43.742 | Corm | MUCC2839 | LC545836 | - |
| Kuala Pilah Tengah, Negeri Sembilan | N 2 41.494 E 102 11.839 | Corm | MUCC2840 | LC545826 | LC545780 |
| Kuala Pilah Tengah, Negeri Sembilan | N 2 41.494 E 102 11.839 | Stem | MUCC2841 | LC545825 | LC545781 |
| Kuala Pilah Tengah, Negeri Sembilan | N 2 41.494 E 102 11.839 | Stem | MUCC2842 | LC545824 | LC545782 |
| Universiti Putra Malaysia, Selangor | N 2 59.510 E 101 42.963 | Stem | MUCC2843 | LC545823 | - |
| Universiti Putra Malaysia, Selangor | N 2 59.510 E 101 42.963 | Stem | MUCC2844 | LC545822 | LC545783 |
| Universiti Putra Malaysia, Selangor | N 2 59.510 E 101 42.963 | Stem | MUCC2845 | LC545821 | LC545784 |
| Universiti Putra Malaysia, Selangor | N 2 59.510 E 101 42.963 | Stem | MUCC2846 | LC545805 | - |
| Kampung Poh, Bidor, Perak | N 4 05.185 E 101 20.019 | Stem | MUCC2847 | LC545820 | LC545785 |
| Kampung Banir, Bidor, Perak | N 4 12.849 E 101 10.580 | Stem | MUCC2848 | LC545819 | LC545786 |
| Kampung Poh, Bidor Perak | N 4 05.185 E 101 20.019 | Root | MUCC2849 | LC545818 | LC545787 |
| Chetok, Kelantan | N 6 02.727 E 100 12.341 | Stem | MUCC2850 | LC545835 | - |
| Chetok, Kelantan | N 6 02.727 E 100 12.341 | Soil | MUCC2851 | LC545834 | - |
| Kampung Perlis, Pulau Pinang | N 5 18.796 E 100 12.341 | Root | MUCC2852 | LC545817 | LC545788 |
| Kampung Perlis, Pulau Pinang | N 5 18.796 E 100 12.341 | Root | MUCC2853 | LC545816 | LC545789 |
| Kampung Karu, Sarawak | N 1 17.119 E 110 16.936 | Stem | MUCC2854 | LC545804 | LC545768 |
| Kampung Pulau Manis, Terengganu | N 5 14.763 E 103 01.730 | Corm | MUCC2855 | LC545799 | LC545771 |
| Kampung Sungai Maong, Sarawak | N 1 32.537 E 110 18.313 | Corm | MUCC2856 | LC545815 | LC545790 |
| Kampung Sungai Maong, Sarawak | N 1 32.537 E 110 18.313 | Corm | MUCC2857 | LC545814 | LC545791 |
| Kampung Karu, Sarawak | N 1 17.119 E 110 16.936 | Corm | MUCC2858 | LC545803 | LC545796 |
| Chetok, Kelantan | N 6 02.727 E 102 08.661 | Corm | MUCC2859 | LC545813 | LC545792 |
| Tumpat, Kelantan | N 6 07.184 E 102 13.275 | Corm | MUCC2860 | LC545812 | LC545793 |
| Tumpat, Kelantan | N 6 07.184 E 102 13.275 | Corm | MUCC2861 | LC545811 | LC545794 |
| Sungai Atong, Pahang | N 3 52.953 E 103 09.777 | Stem | MUCC2862 | LC545810 | LC545798 |
| Kampung Ria Semantan, Pahang | N 3 56.334 E 101 50.423 | Corm | MUCC2863 | LC545809 | LC545795 |
| Kampung Tanjung Besar, Pahang | N 3 28.015 E 102 28.121 | Root | MUCC2864 | LC545808 | LC545796 |
| Kampung Ria Semantan, Pahang | N 3 56.334 E 101 50.342 | Root | MUCC2865 | LC545807 | LC545797 |
| Kampung Ria Semantan, Pahang | N 3 56.334 E 101 50.342 | Corm | MUCC2866 | LC545802 | LC545772 |
| Kampung Ria Semantan, Pahang | N 3 56.334 E 101 50.342 | Corm | MUCC2867 | LC545801 | LC545773 |
| Group | Isolates | Culture Characteristic | Growth Rate (PDA) cm/day | ||
|---|---|---|---|---|---|
| PDA | SNA | CLA | |||
| 1 | MUCC2839 | Magenta pigmentation on both sides of the plate | Sparse mycelia | “Wet” mycelia with pale yellow to orange sporodochia | 0.57 ± 0.20 |
| 2 | MUCC2841 | White colony with cottony and dense mycelia | Floccose mycelia | Sparse mycelia, pale yellow to white sporodochia | 0.60 ± 0.10 |
| 3 | MUCC2867 | White colony with cottony and floccose mycelia | Abundance mycelia | Dense mycelia with yellow sporodochia | 0.48 ± 0.13 |
| 4 | MUCC2858 | White colony with purple pigmentation, floccose and sparse mycelia | Abundance floccose mycelia | Sparse mycelia with yellow to orange sporodochia | 0.52 ± 0.11 |
| Isolates | Macroconidia | Microconidia | ||||||
|---|---|---|---|---|---|---|---|---|
| Length | Width | Septate | Shape | Length | Width | Septate | Shape | |
| MUCC2839 | 15.07–30.99 (24.94 ± 4.09) | 1.39–3.94 (2.59 ± 0.53) | 3–5 | Falcate | 3.58–12.54 (7.02 ± 2.15) | 0.86–2.43 (1.45 ± 0.43) | 0–1 | Oval to ellipsoid |
| MUCC2841 | 16.89–33.84 (25.06 ± 4.94) | 1.76–3.65 (2.32 ± 0.54) | 0–6 | Falcate | 3.29–12.34 (6.97 ± 2.75) | 0.77–2.42 (1.48 ± 0.47) | 0–3 | Oval to ellipsoid |
| MUCC2867 | 19.93–31.85 (25.42 ± 3.65) | 1.03–3.94 (2.38 ± 0.65) | 0–5 | Falcate | 4.78–11.48 (6.13 ± 1.46) | 0.86–2.93 (1.64 ± 0.48) | 0–2 | Oval to ellipsoid |
| MUCC2858 | 16.97–38.07 (26.48 ± 5.41) | 1.25–3.27 (2.24 ± 0.61) | 0–4 | Falcate | 3.79–12.43 (7.14 ± 1.96) | 1.18–2.18 (1.64 ± 0.28) | 0–1 | Oval to ellipsoid |
| Sample Code | H3 | TEF-1α |
|---|---|---|
| MUCC2830 | F. oxysporum | F. oxysporum s. lat. |
| MUCC2831 | F. oxysporum | F. odoratissimum |
| MUCC2832 | F. oxysporum | F. oxysporum |
| MUCC2833 | Not available | F. odoratissimum |
| MUCC2834 | F. oxysporum | F. odoratissimum |
| MUCC2835 | F. oxysporum | F. odoratissimum |
| MUCC2836 | F. oxysporum | F. odoratissimum |
| MUCC2837 | F. oxysporum | F. odoratissimum |
| MUCC2838 | F. oxysporum | F. odoratissimum |
| MUCC2839 | Not available | F. odoratissimum |
| MUCC2840 | F. oxysporum | F. odoratissimum |
| MUCC2841 | F. oxysporum | F. odoratissimum |
| MUCC2842 | F. oxysporum | F. odoratissimum |
| MUCC2843 | Not available | F. odoratissimum |
| MUCC2844 | F. oxysporum | F. odoratissimum |
| MUCC2845 | F. oxysporum | F. odoratissimum |
| MUCC2846 | Not available | F. oxysporum s. lat. |
| MUCC2847 | F. oxysporum | F. odoratissimum |
| MUCC2848 | F. oxysporum | F. odoratissimum |
| MUCC2849 | F. oxysporum | F. odoratissimum |
| MUCC2850 | Not available | F. sacchari |
| MUCC2851 | Not available | F. sacchari |
| MUCC2852 | F. oxysporum | F. odoratissimum |
| MUCC2853 | F. oxysporum | F. odoratissimum |
| MUCC2854 | F. oxysporum | F. oxysporum s. lat. |
| MUCC2855 | F. oxysporum | F. oxysporum |
| MUCC2856 | F. oxysporum | F. odoratissimum |
| MUCC2857 | F. oxysporum | F. odoratissimum |
| MUCC2858 | F. oxysporum | F. oxysporum s. lat. |
| MUCC2859 | F. oxysporum | F. odoratissimum |
| MUCC2860 | F. oxysporum | F. odoratissimum |
| MUCC2861 | F. oxysporum | F. odoratissimum |
| MUCC2862 | F. oxysporum | F. odoratissimum |
| MUCC2863 | F. oxysporum | F. odoratissimum |
| MUCC2864 | F. oxysporum | F. odoratissimum |
| MUCC2865 | F. oxysporum | F. odoratissimum |
| MUCC2866 | F. oxysporum | Fusarium grosmichelii |
| MUCC2867 | F. oxysporum | Fusarium grosmichelii |
| Banana Cultivar (Genome Type) | Pathogenicity Rating | Notes | |
|---|---|---|---|
| Leaf a | Corm b | ||
| Musa acuminata cv. ‘Dwarf Cavendish’ (AAA) | 3 | 5 | Discolouration of younger leaves; pseudostem splitting; corm rot and discolouration. |
| Musa acuminata cv. ‘Lakatan’ (AA) | 4 | 6 | All leaves yellowing; pseudostem splitting; corm rotted and discoloured. |
| Musa × paradisiaca cv. ‘Raja’ (AAB) | 1 | 5 | Initial yellowing on older leaves; pseudostem splitting; corm rot and discolouration. |
| Musa × paradisiaca cv. ‘Laknau’ (AAB) | 2 | 5 | Older leaves yellowing; pseudostem splitting; corm rot and discolouration. |
| Musa × paradisiaca cv. Saba (ABB) | 2 | 5 | Older leaves yellowing; pseudostem splitting; corm rot and discolouration. |
| Banana Cultivar (Genome Type) | Leaf | Corm | ||
|---|---|---|---|---|
| Control | Inoculated | Control | Inoculated | |
| Musa acuminata cv. ‘Dwarf Cavendish’ (AAA) | 26.38 a | 97.91 d | 0 a | 94.44 c |
| Musa acuminata cv. ‘Lakatan’ (AA) | 25.00 a | 70.07 c | 0 a | 88.89 b |
| Musa × paradisiaca cv. ‘Raja’ (AAB) | 25.00 a | 69.23 c | 0 a | 83.33 b |
| Musa × paradisiaca cv. ‘Laknau’ (AAB) | 25.00 a | 67.29 bc | 0 a | 83.33 b |
| Musa × paradisiaca cv. Saba (ABB) | 25.00 a | 59.23 b | 0 a | 83.33 b |
Publisher’s Note: MDPI stays neutral with regard to jurisdictional claims in published maps and institutional affiliations. |
© 2021 by the authors. Licensee MDPI, Basel, Switzerland. This article is an open access article distributed under the terms and conditions of the Creative Commons Attribution (CC BY) license (https://creativecommons.org/licenses/by/4.0/).
Share and Cite
Ujat, A.H.; Vadamalai, G.; Hattori, Y.; Nakashima, C.; Wong, C.K.F.; Zulperi, D. Current Classification and Diversity of Fusarium Species Complex, the Causal Pathogen of Fusarium Wilt Disease of Banana in Malaysia. Agronomy 2021, 11, 1955. https://doi.org/10.3390/agronomy11101955
Ujat AH, Vadamalai G, Hattori Y, Nakashima C, Wong CKF, Zulperi D. Current Classification and Diversity of Fusarium Species Complex, the Causal Pathogen of Fusarium Wilt Disease of Banana in Malaysia. Agronomy. 2021; 11(10):1955. https://doi.org/10.3390/agronomy11101955
Chicago/Turabian StyleUjat, Anysia Hedy, Ganesan Vadamalai, Yukako Hattori, Chiharu Nakashima, Clement Kiing Fook Wong, and Dzarifah Zulperi. 2021. "Current Classification and Diversity of Fusarium Species Complex, the Causal Pathogen of Fusarium Wilt Disease of Banana in Malaysia" Agronomy 11, no. 10: 1955. https://doi.org/10.3390/agronomy11101955
APA StyleUjat, A. H., Vadamalai, G., Hattori, Y., Nakashima, C., Wong, C. K. F., & Zulperi, D. (2021). Current Classification and Diversity of Fusarium Species Complex, the Causal Pathogen of Fusarium Wilt Disease of Banana in Malaysia. Agronomy, 11(10), 1955. https://doi.org/10.3390/agronomy11101955






